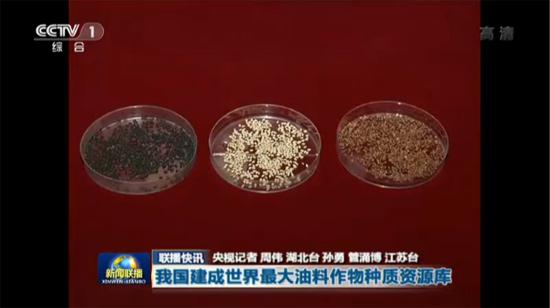

[新闻联播]我国建成世界最大油料作物种质资源库
发布时间: 2017-04-10
来源:中央电视台2017年4月9日《新闻联播》
作者:周伟 孙勇 管涌博
2017年4月9日,中央电视台《新闻联播》栏目联播快讯头条报道了油料所建成世界最大油料作物种质资源库情况,内容如下:
中国农科院油料作物研究所日前建成世界最大的油料作物种质资源库,共收集保存国内外油菜、花生、大豆等种质30426份,在推进油菜、花生、芝麻高油育种、抗性遗传改良等研究方面跃居国际领先行列。

视频链接:http://tv.people.com.cn/n1/2017/0409/c61600-29197895.html